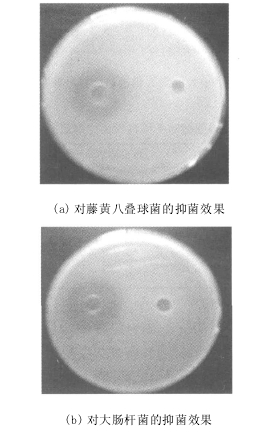

| 金銀花中綠原酸的體外抑菌和抗氧化性的研究 |
| 發(fā)布時(shí)間:2013-12-19 信息來源:admin 發(fā)布人:admin 點(diǎn)擊次數(shù):2806 |
摘 要:用紫外光譜法(UV)和高效液相色譜法(HPLC)對金銀花中提取的綠原酸進(jìn)行定性定量分析,測定了綠原酸對食品中常見的致病菌的抑菌能力,清除DPPH·自由基的能力和對Fe3+的還原能力。結(jié)果表明:金銀花中綠原酸具有較強(qiáng)的抑菌效果,對自由基有較強(qiáng)的清除能力,對Fe3+有較強(qiáng)的還原能力。 關(guān)鍵詞:金銀花;綠原酸;抑菌;抗氧化 金銀花在我國分布廣,藥用歷史悠久,是常用的清熱解毒藥。金銀花為忍冬科(Caprifoliaceae)忍冬屬(Lonicera)植物忍冬(Lonicera japonica thunb)及同屬多種植物的干燥花蕾,是臨床常用的中藥之一。近年來研究發(fā)現(xiàn),金銀花中富含多種對人體健康有益的物質(zhì),諸如揮發(fā)油黃酮及綠原酸類、三萜類和微量元素等,具有很高的利用價(jià)值。在眾多的成分中綠原酸較為豐富且具有多種活性功能,因此常以綠原酸含量的高低評價(jià)金銀花質(zhì)量的優(yōu)劣。 綠原酸是一種含有酚羥基的化合物,藥理學(xué)證明,綠原酸具有保護(hù)心血管的活性。人體內(nèi)的低密度脂蛋白(LDL)被氧化是引起心血管病的一個(gè)重要原因。綠原酸能有效地保護(hù)人體LDL中α-Tocopher o,l使其LDL免受氧化。當(dāng)人體攝入一定量含有酚羥基化合物的食物時(shí),這些物質(zhì)可降低或淬滅人體中自由基的產(chǎn)生。據(jù)統(tǒng)計(jì)在心臟病低發(fā)病率的人群中,發(fā)病率與綠原酸的攝入有一定聯(lián)系,其部分抗病機(jī)制是綠原酸對人體LDL中αTocopherol氧化的抑制作用。 本文在對金銀花中綠原酸的抗菌、抗氧化活性等方面做一些探討,為工業(yè)化生產(chǎn)該類物質(zhì)提供一定的技術(shù)依據(jù)。 1 材料和方法 1.1 材料與儀器 1. 1. 1 試驗(yàn)材料 河南產(chǎn)金銀花,經(jīng)干燥后破碎。 1. 1. 2 試驗(yàn)菌株 大腸埃希氏菌(Escherichia Coli,G-),枯草芽胞桿菌(Bacillus subtilis,G+),金黃色葡萄球菌(Staphylo coccus aureus, G+),藤黃八疊球菌(Microccus luteus (Schroeter)Cohn,G+)購自于湖北武漢大學(xué)中國典型培養(yǎng)物保藏中心。 1. 1. 3 培養(yǎng)基 固體肉湯培養(yǎng)基(g/L):蛋白胨10. 0,牛肉浸膏5. 0,NaCl5. 0,瓊脂20. 0, pH 7. 2, 121℃滅菌20min;半固體肉湯培養(yǎng)基(g/L):蛋白胨10. 0,牛肉浸膏5. 0,NaCl5. 0,瓊脂8. 0, pH 7. 2, 121℃滅菌20 min。 1. 1. 4 實(shí)驗(yàn)儀器 KDF2116康達(dá)多功能食品粉碎機(jī)(天津市達(dá)康電器公司),微量進(jìn)樣器(基因公司),ORION 818型pH計(jì)(美國), RE3000旋轉(zhuǎn)蒸發(fā)器(上海亞榮生化儀器), SHBⅢ循環(huán)水式多用真空泵(鄭州長城科工貿(mào)), AB204N分析天平(美國MettlerToledoGroup),Uvmini1240紫外可見分光光度計(jì)(日本島津有限公司),高效液相色譜儀(美國Lab)。 1. 1. 5 主要試劑 CH3CH2OH、NaCl、FeCl3、K3Fe(CN)6、Na2HPO4、NaH2PO4、綠原酸標(biāo)準(zhǔn)品、2, 2-二苯基-α-苦基肼(DPPH)、抗壞血酸、三乙胺、三氯乙酸(均為分析純),乙腈(色譜純);慶大霉素(華北制藥廠,生產(chǎn)批號:20040218, 80萬單位/2mL),大孔樹脂(南開大學(xué)化工廠)。 1.2 實(shí)驗(yàn)方法 1. 2. 1 綠原酸的基本提取工藝 金銀花破碎顆!鸁峄亓鹘帷鷿饪s→冷沉→離心→大孔樹脂純化→濃縮→冷藏保備用。 1. 2. 2 紫外分光光度法對金銀花中綠原酸含量的測定 將綠原酸標(biāo)準(zhǔn)溶液配成濃度0. 01 mol/L,用紫外分光光度計(jì)于200~500 nm掃描。選取綠原酸的最大吸收波長,測定不同濃度標(biāo)準(zhǔn)溶液的吸光度值,做出標(biāo)準(zhǔn)曲線,以計(jì)算金銀花中綠原酸的含量。 1. 2. 3 對金銀花中綠原酸的定性分析 本試驗(yàn)利用高效液相色譜法(HPLC)在相同色譜條件下,將標(biāo)準(zhǔn)溶液色譜圖與樣品色譜圖進(jìn)行對照,根據(jù)保留時(shí)間確定樣品中的綠原酸。 1. 2. 4 綠原酸抑菌活性實(shí)驗(yàn)———生物檢測法 抑菌試驗(yàn)方法:無菌操作。取10 mL瓊脂培養(yǎng)基于直徑為9 cm的無菌培養(yǎng)皿中,鋪勻,待凝固后,放入兩個(gè)牛津杯。取含有活菌的半固體培養(yǎng)基10 mL,加到裝有牛津杯的培養(yǎng)皿中,鋪勻,待凝固后,拔出牛津杯,在其中一個(gè)杯孔中加入藥液50μL,并設(shè)陰性對照和陽性對照, 37℃培養(yǎng)24 h觀察結(jié)果,并測量抑菌環(huán)直徑。抑菌環(huán)直徑≥20 mm為極敏, 15~20 mm為高敏, 10~15 mm為中敏,≤10 mm為低敏。 1. 2. 5 綠原酸抗氧化性 本實(shí)驗(yàn)利用還原法測定了金銀花中綠原酸在體外清除2, 2-二苯基-α-苦基肼自由基(DPPH·)的能力,并與抗壞血酸進(jìn)行了還原Fe3+能力的對比。 (1)綠原酸清除DPPH·活性測定 取0. 1 mL的精制綠原酸樣品溶液,加入2. 9 mL0. 05g/L的DPPH·乙醇溶液;靹蚝笤517 nm處測定吸光度值,每1 min測量一次,直至讀數(shù)穩(wěn)定。 (2)綠原酸還原Fe3+能力的測定[7] 取2. 5 mL的不同樣品溶液,加入2. 5 mL的磷酸鹽緩沖液(0. 2 mol/L, pH =6. 6)及2. 5 mL的10-0K3Fe(CN)6溶液,于50℃水浴反應(yīng)20 min后急速冷卻,加入2. 5 mL的1000三氯乙酸溶液,取反應(yīng)液5 mL,加入5 mL的H2O和0. 100FeCl3溶液1 mL,混合均勻, 10 min后于700 nm處測定其吸光度值,以水為空白,吸光度值越大表示還原能力越強(qiáng)。以上實(shí)驗(yàn)均以抗壞血酸作陽性對照。 2 結(jié)果與討論 2.1 金銀花中綠原酸的測定 通過對綠原酸標(biāo)準(zhǔn)溶液和在金銀花中精制所得的綠原酸溶液用紫外分光光度計(jì)在200~500 nm掃描,見圖1。由圖1可以看出,由大孔吸附樹脂精制所得的綠原酸和相同濃度的綠原酸標(biāo)準(zhǔn)品的紫外光譜圖比較,二者都是在324 nm有一最大吸收峰,峰形和兩峰峰高比例基本相同。最后選取最大吸收波長324 nm,再分別測定不同濃度標(biāo)準(zhǔn)綠原酸溶液的吸光度值,以綠原酸標(biāo)準(zhǔn)品濃度為橫坐標(biāo),以其吸光度值為縱坐標(biāo)繪制標(biāo)準(zhǔn)曲線,如圖2。 根據(jù)所繪的標(biāo)準(zhǔn)曲線,求得線性回歸方程為Y=57.497x+0.048 2,且相關(guān)系數(shù)R2=0.999 9,說明本方法在綠原酸的質(zhì)量濃度為0. 005~0. 030 g/L時(shí)具有良好的線性關(guān)系。 利用大孔吸附樹脂對粗提液進(jìn)行的純化使得產(chǎn)品的純度由原來37. 99%提高到90. 38%,精制得率達(dá)90%以上。
結(jié)果表明, 1. 0 g/L的金銀花中綠原酸的抑菌效果明顯,尤其是大腸桿菌和藤黃八疊球菌,它們的抑菌圈直徑分別是25. 95 mm和23. 55 mm即為極敏,金黃色葡萄球菌的抑菌圈直徑是19. 72 mm為高敏,枯草芽胞桿菌抑菌圈直徑是13. 65 mm為中敏。慶大霉素雖對一些致病菌等具有強(qiáng)抑菌作用,但它對人體有腎 毒性、耳毒性、過敏反應(yīng)等,而在金銀花中提取的綠原酸的毒副作用還未見文獻(xiàn)報(bào)道,又因?yàn)榻疸y花來源豐富、價(jià)格低廉,所以金銀花與慶大霉素等比較,在臨床應(yīng)用上更為安全、方便,可供臨床選用防治致病菌等感染的參考。 2.4 綠原酸抗氧化性 2. 4. 1 綠原酸清除DPPH·測定 20世紀(jì)80年代,自由基對健康的影響日益為人們所認(rèn)識,現(xiàn)代醫(yī)學(xué)和營養(yǎng)保健學(xué)認(rèn)為,自由基在人體內(nèi)可直接引起許多疾病,而且與其他一些疾病的發(fā) 生也有關(guān)。 綠原酸是具有酚羥基的一類還原性化合物,在復(fù)雜反應(yīng)體系中,由于其自身被氧化而具有抗氧化作用。其途徑就是綠原酸分子的酚羥基與有害自由基反應(yīng)變成較穩(wěn)定的半醌式自由基,從而終止有害自由基的鏈?zhǔn)椒磻?yīng);其次是綠原酸通過自身的還原性質(zhì)直接給出電子消耗掉有害自由基。深入研究綠原酸的抗氧化機(jī)理,對天然抗氧化劑的篩選,改進(jìn)抗氧化劑的結(jié)構(gòu),獲取性能更加優(yōu)良的抗氧化劑具有重要意義。 2, 2-二苯基-α-苦基肼自由基(DPPH·)是一種很穩(wěn)定的以氮為中心的自由基,若受試物能將其清除,則表示受試物具有降低羥自由基、烷自由基或過氧化自由基的有效濃度和打斷脂質(zhì)過氧化鏈反應(yīng)的作用。DPPH·有個(gè)單電子,在517 nm有強(qiáng)吸收,其乙醇溶液呈深紫色,加入受試物后,在517 nm處可以動態(tài)監(jiān)測其對DPPH·的清除效果。綠原酸和抗壞血酸的清除DPPH·能力如圖6所示。
綠原酸與抗壞血酸清除DPPH·能力隨時(shí)間的延長而增強(qiáng),在反應(yīng)到5min以后,綠原酸與抗壞血酸基本將DPPH·清除完全,而且綠原酸清除DPPH·能力比抗壞血酸要強(qiáng)。由此可以看出,綠原酸與自由基反應(yīng),能使自由基成為更為穩(wěn)定的物質(zhì);綠原酸屬于能與自由基快速反應(yīng)的小分子化合物,因此它是潛在重要的生物抗氧化劑。 2. 4. 2 綠原酸和抗壞血酸還原力的比較 還原能力的測定,可檢驗(yàn)化合物是否為良好的電子供應(yīng)者。它所供應(yīng)的電子可以使Fe3+還原為Fe2+,使體系溶液顏色改變,即可反映出體系中氧化還原狀態(tài)的改變。加入化合物后,在700 nm處可以推知體系中Fe3+的變化。 綠原酸和抗壞血酸還原Fe3+的能力如圖7所示。由圖7可以看出,體系溶液在較低的濃度時(shí),綠原酸與抗壞血酸還原能力隨濃度的增加而增強(qiáng),而綠原酸的還原能力強(qiáng)于抗壞血酸。
3 結(jié) 論 利用牛津杯法測得1. 0 g/L金銀花中綠原酸的抑菌結(jié)果為:大腸桿菌、藤黃八疊球菌對于綠原酸為極敏,金黃色葡萄球菌為高敏,枯草芽胞桿菌中敏。 從清除DPPH·能力上比較,綠原酸表現(xiàn)出了比抗壞血酸強(qiáng)的清除能力,并且隨其濃度的增加清除能力呈上升趨勢;從還原力上比較,較低濃度的綠原酸也遠(yuǎn)高出抗壞血酸的還原力。 |





金銀花中綠原酸的體外抑菌和抗氧化性的研究